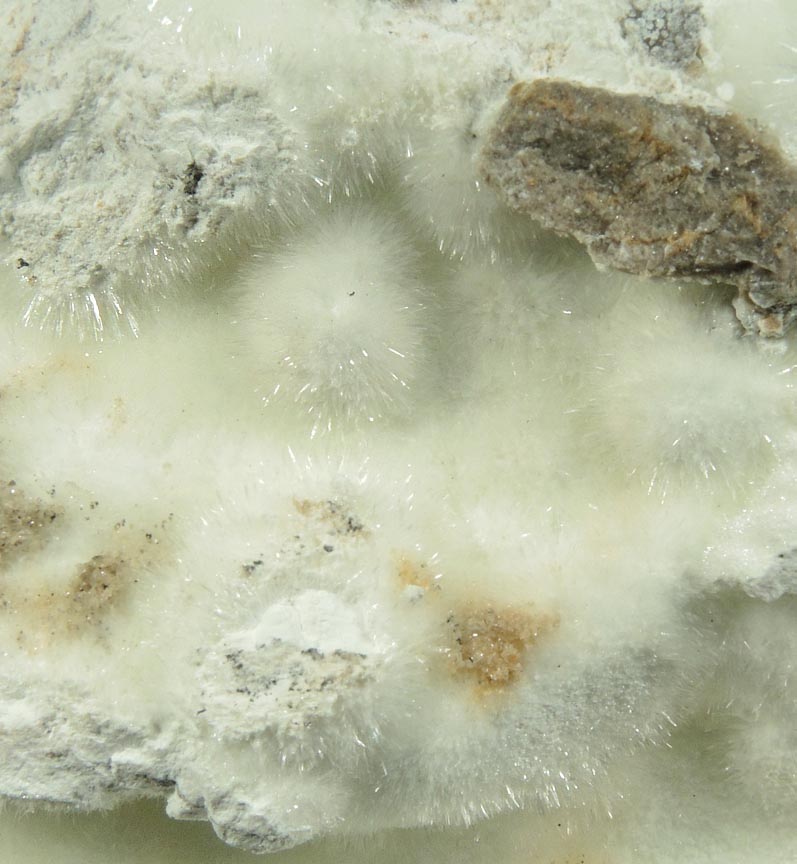

Hydrozincite from Yellow Pine Mine, Goodsprings District, Clark County, Nevada
Photo below under shortwave ultraviolet illumination:
 |
Photo below under longwave ultraviolet illumination:
 |
| DESCRIPTION: | No. 78295
|
| Mineral: | Hydrozincite
|
| Locality: | Yellow Pine Mine, Goodsprings District, Clark County, Nevada |
| Description: | Large specimen of pristine white acicular hydrozincite crystals lining shallow cavities in hydrozincite-coated matrix. The hydrozincite fluoresces bright white under SW UV illumination and orange-white under LW UV illumination. Ex. Earl Verbeek collection; collected in 1994 by Kim Cathcart |
| Overall Size: | 10.5x8.5x3.5 cm |
| Crystals: | 0.5-3.0 mm |
| Archived: | For reference only |
© AllMinerals/JohnBetts-FineMinerals All Rights Reserved
The minerals illustrated on this site are presented for reference purposes only. The owner of this site did not collect the minerals and collectors should not assume access is permitted to the property based on inclusion in this museum. Please contact the property owner to obtain legal permission before entering private property.